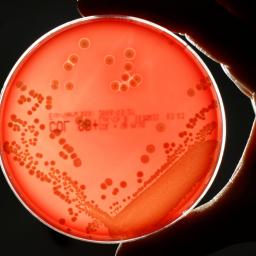

|
by GrrlScientist on (#510E)
In today’s “Museum Monday†video, we watch a time-lapse as a coral reef aquarium is set up in the Natural History Museum’s Jerwood Gallery. This aquarium will be featured in their upcoming exhibition where the public can learn about the importance of marine coral reef communities. Continue reading...
|
| Link | http://feeds.theguardian.com/ |
| Feed | http://feeds.theguardian.com/theguardian/science/rss |
| Updated | 2026-06-30 22:30 |
 |
by Stian Westlake on (#50RF)
Innovate UK, the £500m quango responsible for funding innovation and technology, has appointed Ruth McKernan as its new CEO. Stian Westlake offers her five ideas for the organisation’s future. Continue reading...
|
by Samuel Gibbs on (#50NW)
Pioneering solid-state batteries could hold twice as much electricity as current batteries for longer-lasting smartphones, tablets and electric cars Continue reading...
 |
by Tom Kerss (Royal Observatory, Greenwich) on (#505X)
Continue reading...
|
 |
by Dalya Alberge on (#5018)
Wiltshire monument may have been equivalent of ‘an ancient Mecca on stilts’ according to an idea put forward by former museum director Julian SpaldingWhether it was a Druid temple, an astronomical calendar or a centre for healing, the mystery of Stonehenge has long been a source of speculation and debate. Now a dramatic new theory suggests that the prehistoric monument was in fact “an ancient Mecca on stiltsâ€.The megaliths would not have been used for ceremonies at ground level, but would instead have supported a circular wooden platform on which ceremonies were performed to the rotating heavens, the theory suggests.
|
 |
by Ian Sample Science editor on (#4ZSK)
Rare event will blot out the sun in Faroe Isles while best place to watch it in the UK, the Isle of Lewis, prepares for public viewingSolar eclipse 1999 - in pictures
|
 |
by Ranjit Dhaliwal on (#4ZK2)
Ahead of the forthcoming solar eclipse visible in the far north of Scotland, we look back at the total solar eclipse on 11 August 1999, one of the most widely viewed in history
|
 |
by Libby Brooks Scotland reporter on (#4ZF1)
Friday’s eclipse will not touch land anywhere across the UK, but the line of totality will pass six miles north-west of the uninhabited island of Rockall Continue reading...
|
 |
by Jonathan Margolis on (#4Z6T)
In 1977, Voyager 1 and 2 started their one-way journey across our galaxy, travelling a million miles a day. Jonathan Margolis meets the dedicated team keeping the craft movingOn a chilly March morning, Steve Howard, aged 65, is at work in his office on the northern edge of Pasadena, California. Two computer screens are squeezed on to his corner desk along with family photos, a tissue box and tins of Altoids Curiously Strong Peppermints. The office is in a quiet business park by a workaday main road. Next to it is a McDonald’s, where people linger for hours over a $1 coffee, seemingly to keep warm. Over the road there’s a scruffier burger joint, Jim’s, with an M missing from its sign – and, visible from Howard’s window, a landscaping supplies yard.If the few people walking by on West Woodbury Road, Altadena, or popping into the landscaping place for some patio paving slabs were to peer into Howard’s office, they might guess, seeing the graph-covered twin screens and a third PC at the other end of the desk, that he was, perhaps, a financial adviser or a day trader. But what Steve Howard is actually doing makes this very ordinary all-American scene quite extraordinary. Continue reading...
|
 |
by Quentin Wheeler on (#4Z55)
Long mistaken for another species, this Australian marsupial may now be under threat from rising temperatures. That doesn’t stop it from enjoying a vigorous, if deadly, sex life Continue reading...
|
 |
by Sarah Main on (#4YSD)
The political parties may argue passionately that science is our future, but let’s see some real action to promote it Continue reading...
|
 |
by Robin McKie on (#4YS1)
Next month, 170 years after the Erebus and all its crew were lost, experts will try to reach the wreck – under thick ice on an undersea ridge Continue reading...
|
 |
by Stuart Clark on (#4YA7)
The European Space Agency’s ambitious mission to fly closer to the Sun than ever before is now ready for testing, ahead of its 2017 launchIt is hard not to be impressed with the spacecraft standing in the clean room at Airbus Defence and Space, Stevenage. It is a test model for a spacecraft that will travel closer to the Sun than any mission yet flown.
|
by Gareth Ffowc Roberts on (#4XR2)
Anglesey-born William Jones was the first person to use the Greek letter π for the ratio of a circle’s circumference to its diameter. But who was this little-known figure? Continue reading...
 |
by Dean Burnett on (#4Y20)
Australian Prime Minister Tony Abbott recently caused much confusion by publicly eating a raw onion in the manner people would usually eat apples, with no complaint or objection. Whilst baffling to many, this may be one instance where science supports Tony Abbott’s actions. Continue reading...
|
 |
by Duncan McLaren on (#4Y11)
As geoengineering researchers gather for a conference in Cambridge, Duncan McLaren draws lessons from ethics and science fiction to make a case for caution Continue reading...
|
 |
by GrrlScientist on (#4XZR)
Since today is “Caturdayâ€, I had to share some videos of one of my favourite birds in the world, the diminutive budgerigar named Disco. And because Disco is such a talented mimic, this gives me the opportunity to share the evolutionary reasons why pet parrots mimic people. Continue reading...
|
 |
by James Grime on (#4XYP)
Pi Day 2015: A well known fact about pi is that it describes the bendiness of rivers. I wanted to test this theory, and so I crowd-sourced river lengths to find out Continue reading...
|
 |
by Chris Mooney for the Washington Post on (#4XTG)
The Chinchorro people of Chile preserved bodies long before the Egyptians. But their remains may be falling foul of a very modern problem Continue reading...
|
 |
by Toby Smith on (#4W8C)
Photographer Toby Smith goes behind the scenes with the satellite engineers taking giant leaps into a world beyond our reach
|
 |
by Photography and videos: Toby Smith. Words: Andrew on (#4WMB)
Forget missions to Mars, satellite technology is the real space race, with the number in orbit set to double in the next decade. So what goes on behind the scenes?
|
by Alex Bellos on (#4WGA)
Akira Haraguchi, 69, is a legend among memory masters, having memorised more of pi’s digits than anyone else. Here he talks about why he does it and how he will be celebrating pi’s big dayPi Day 2015: A sweet treat for mathematics fans
 |
by Alex Bellos on (#4WDK)
Ratio of a circle’s circumference to its diameter has sparked memory contests and even a language – this year’s celebration of π is a once-in-100-year occasionHe ate all the pi : Japanese man memorises π to 111,700 digitsA date falls on this Saturday that only comes once every 100 years – and geeks around the world are very excited.It’s Pi Day, the celebration date of the number that is the ratio of a circle’s circumference to its diameter. The celebration is held annually on 14 March, because 3/14 spells out the first three digits of π, or pi, which is 3.14. Continue reading...
|
 |
by Hervé Morin on (#4WAF)
Naturalists decamp to remote Amazonian region to try to classify some of the many thousands of unidentified Guianan species Continue reading...
|
by Guardian Staff on (#4W1C)
The Large Hadron Collider (LHC) is now new and improved and ready to conduct science research again, say the scientists of the European Centre for Nuclear Research (Cern) on Thursday in Geneva. the LHC was shut down for upgrades in 2013, after the discovery of the long-sought Higgs Boson in 2012. Scientists say the mystery dark matter will be a prime research target for the coming years Continue reading...
 |
by GrrlScientist on (#4VZG)
This week’s books include three scholarly works: one examines the language of science and how it changed from Latin to English; another probes the rise of online universities; and a third discusses the use of Victorian fairy-tales to communicate science to public. Continue reading...
|
 |
by Nicola Davis on (#4VYM)
What will happen to human skill and sensibility as robots take on more tasks and aspects of human existence? What are the challenges facing inhabitants of remote Pacific Ocean islands, and why does 1610 mark a new human epoch? Continue reading...
|
 |
by Guardian Staff on (#4VP3)
The Iron Man star Robert Downey Jr gives a seven-year-old boy a bionic arm. In a video posted on his Facebook page, the actor can be seen dressed as Tony Stark, Iron Man's alter ego. In partnership with Limbitless Solutions, Downey Jr presents a 3D-printed bionic arm to young Alex, who was born with a partially developed arm Continue reading...
|
 |
by Reuters on (#4VK6)
First space mission dedicated to study of magnetic reconnection – thought to be the catalyst for some of the most powerful explosions in solar system
|
 |
by Jenny RohnStephen CurryAndrew Steele on (#4VG4)
Tell Them Science is Vital: with funding in decline and an election looming, we must make sure our democratic representatives understand how crucial science is for our economy, health and happiness Continue reading...
|
by Daniel Hurst Political correspondent on (#4V8W)
As Senate prepares to debate university fee deregulation, education minister faces mounting criticism over threat to slash $150m in funding if bill not passed Continue reading...
 |
by Melissa Davey and agencies on (#4VFY)
Queensland has recorded 1,895 cases of salmonella so far this year, and authorities say misconceptions about dirty eggs are part of the problem Continue reading...
|
 |
by Hannah Devlin, science correspondent on (#4VBW)
Study to sequence genes of 100,000 people from Pakistani and Bangladeshi communities to identify genes resilient to heart disease, diabetes and cancerScientists are planning to sequence the genes of 100,000 south Asian people in London, in an ambitious project to track down rare beneficial genes that protect against conditions from heart disease to cancer.The Pakistani and Bangladeshi communities in London have among the highest rates of poor health in Britain, with twice the average number of deaths from heart disease and five times the rate of type 2 diabetes. But within this population, scientists predict, there will be people who are unexpectedly healthy, whose genes could be conferring extreme resilience to disease. Continue reading...
|
 |
by Kareem Shaheen in Beirut on (#4T3P)
Attack on Dur-Sharrukin, the latest by group on country’s heritage, comes as Brussels calls for creation of safe havens for Iraqi minorities Continue reading...
 |
by Associated Press in Cape Canaveral, Florida on (#4TKZ)
The two-year mission’s findings should help scientists better understand so-called space weather as liftoff is set for Thursday night Continue reading...
|
 |
by Agence France-Presse in Rome on (#4TJD)
Forensic team says it used handkerchief splashed with Gabriele D’Annunzio’s sperm to recreate eccentric, 19th-century, rightwing leader’s genetic blueprint Continue reading...
|
 |
by Ian Sample, science editor on (#4TGV)
LHC will run at double its previous energy, smashing protons to open up the subatomic world and look for more varieties of Higgs boson
|
by Pete Etchells and Chris Chambers on (#4TG9)
An autism researcher and an Oxford professor have exposed what appears to be a substantial case of academic malpractice, highlighting the vital role of peer review and the dangers faced by whistle-blowers Continue reading...
 |
by Dean Burnett on (#4TCG)
The death of Terry Pratchett from early onset Alzheimer’s is a bitter blow for many. But his life and legacy will always be cause for celebration
|
 |
by Rowena Mason Political correspondent on (#4TB3)
Animal rights groups accuse government of betrayal after minister announces ban on animal testing of cleaning products but not ingredientsThe government has been accused of introducing a useless ban on using animals to test cleaning products after it emerged that the new prohibition will not apply to testing ingredients.The coalition promised to end animal testing on household products in its programme for government in 2010. On Thursday Lynne Featherstone, a Home Office minister, announced that the ban would come into force in October but said it would not apply to the ingredients that go into the products, which include detergents, polishes and cleaning products, laundry products, household cleaners, air fresheners and toilet cleaners. Continue reading...
|
by Reuters on (#4S2W)
Rodents found to have improved memories after ultrasound treatment, without any apparent damage to brain tissue Continue reading...
 |
by GrrlScientist on (#4SVX)
Plants capture sunlight and turn it into starch. Scientists are now adapting the photosynthetic process to improve the way we harness solar energy Continue reading...
|
 |
by Guardian Staff on (#4SQD)
The Soyuz TMA-14M capsule landed safely in Kazakhstan just after sunrise, returning home the two Russian and one US crew member who have spent 167 days in orbit Continue reading...
|
|
by Dean Burnett on (#4SR6)
Following on from Nigel Farage’s claims that anti-discrimination laws are no longer needed in the UK, concerns about antibiotic resistance and investment in healthcare have been dismissed as irrelevant and wasteful by numerous deadly diseases Continue reading...
|
 |
by Edzard Ernst on (#4SR8)
Pharmacists who sell homeopathic remedies as anything other than placebos are putting their customers’ health at risk
|
 |
by Mark Lynas on (#4S7N)
Alarmists and deniers need to climb out of their parallel trenches, engage with the developing world and work together to end the crisis Continue reading...
|
 |
by Lewis Smith on (#4S4Y)
Rough periwinkles found commonly around UK coast described as new species or sub-species over 100 timesA seaside snail found in rock pools on almost every stretch of coast around the UK has been named as the most misidentified creature in the world.Rough periwinkles are commonly seen on shorelines around the North Atlantic but come with so many colour and shape variations that they have confused scientists for centuries. Continue reading...
|
 |
by Guardian Staff on (#4R8M)
Nasa test-fires a beefed-up space shuttle Solid Rocket Motor in Utah on Wednesday. The 177-foot motor is 25% more powerful than the four-segment engines used to help lift the space shuttle. The two-minute test fire is considered a key milestone toward the debut flight of Nasa's deep-space launcher in 2018 Continue reading...
|
 |
by Bob O'HaraGrrlScientist on (#4R7Y)
A new paper investigates when humans started screwing up the environment, and uses this as the symbol for the beginning of a new geologic age: the Anthropocene, or the Age of Humans. Continue reading...
|